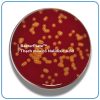

MỤC ĐÍCH SỬ DỤNG
- BacterPlate™ Thạch máu (BA) Là môi trường nuôi cấy đa năng được sử dụng rộng rãi để nuôi cấy và phân lập nhiều loại vi sinh vật. Nó đóng vai trò quan trọng trong chẩn đoán in vitro và kiểm tra chất lượng vi sinh vật. Hơn nữa, môi trường này giúp phân biệt các loài vi khuẩn dựa trên phản ứng tiêu huyết (tiêu huyết α, β và ɤ)
- Bao gói bằng màng bán thấm Cellophane film giúp cân bằng độ ẩm môi trường trong quá trình bảo quản.
NGUYÊN TẮC
- Peptones trong thành phần môi trường thúc đẩy sự phát triển tối ưu của các khuẩn lạc.
- Chiết xuất nấm men là nguồn cung cấp vitamin B phức hợp.
- Tinh bột có vai trò làm chất khử độc và cũng là nguồn năng lượng.
- Máu cừu khử sợi huyết cung cấp yếu tố X (heme), cần thiết cho sự phát triển của nhiều vi khuẩn khó tính, và cho phép phát hiện các phản ứng tiêu huyết.

English